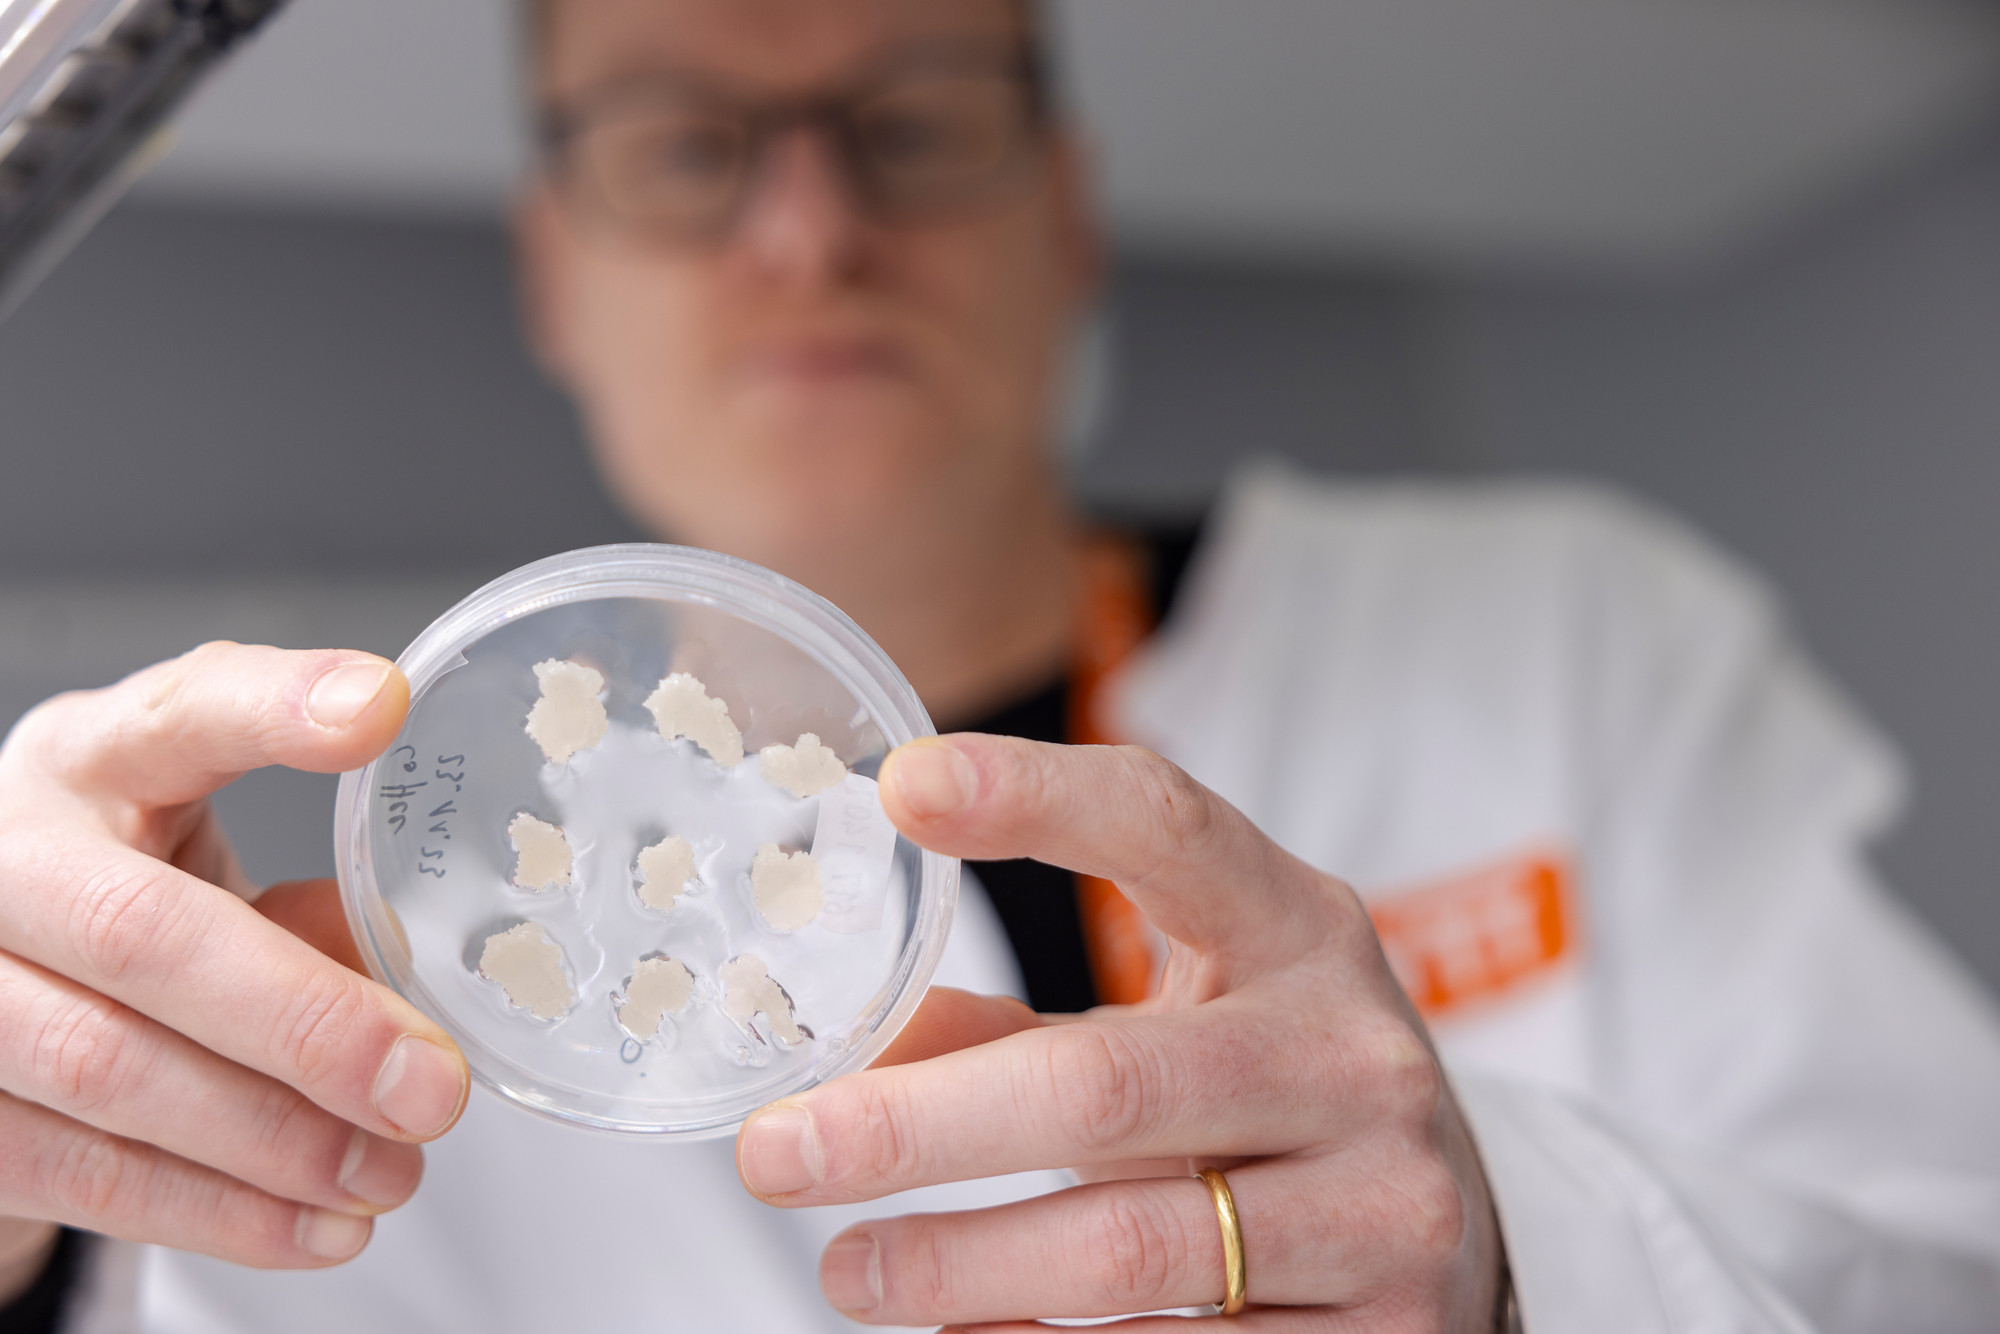
Ensure that logos are correct and nothing confidential is visible

Videos
People respond better to visual information than text alone. Therefore, videos play an essential role in communicating the VTT brand and getting our message out. When creating videos, make sure that all the materials shown in the videos are in line with our brand guidelines (imagery or illustration style, typography, logos, colours, protective equipment, safety, etc.). To ensure accessibility, use text that is easy to read, pay attention to contrast and avoid fast-flashing content. Always provide captions to your video.
Storyline
All VTT videos should have a natural and journalistic touch, and they should focus on telling a powerful but positive story.
Open your video with an image and title so audience knows what to expect. Pay attention to the structure: present the potential challenge or case, tell how we at VTT can help or share our insights, and what we can achieve together. Summarise the key points and include a call to action. Always use VTT outro in the end.
We have also pattern animations that can be used in transitions, but are not compulsory.

Name plates
When presenting speakers in videos, webinars or in other digital events, use VTT's fonts, simple shapes, and brand colours thoughtfully and with good contrast.
For selected virtual events, name plates can be spiced up with patterns to match them with the whole event identity.